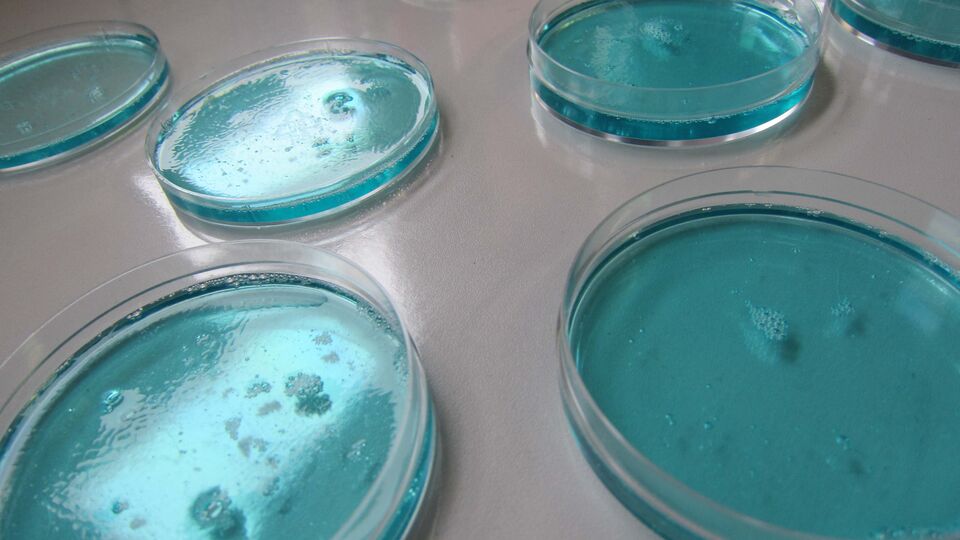
slider_img3029

Textilelektronik ist eine erfolgreiche Symbiose aus Elektrotechnik und Textil- und Bekleidungstechnik.
Dafür gibt es unzählige innovative Anwendungsbeispiele in den Bereichen Fashion und Mode, Wearables, Sport, Lifestyle, Automotiv, Medizin und Healthcare, Umweltschutz, Nachhaltigkeit, Architektur, Heimtextilien und Innenraumdesign, Logistik und vieles mehr.
Die Fachbereiche Elektrotechnik und Informatik und Textil- und Bekleidungstechnik verfügen über langjährige Erfahrungen im Bereich Smart Textiles, funktionale Beschichtungen und Mikro- und Nanotechnologie. An der Hochschule besteht daher eine enge Kooperation der Fachbereiche, so dass auch elektronische Bauteile auf und aus Textil realisiert werden können.
Hierzu zählen flexible Lichtemitter auf Textil, Heiztextilien und andere Aktoren ebenso wie textile Batterien, Solarzellen, Elektroden, Datenleiter und Sensoren.